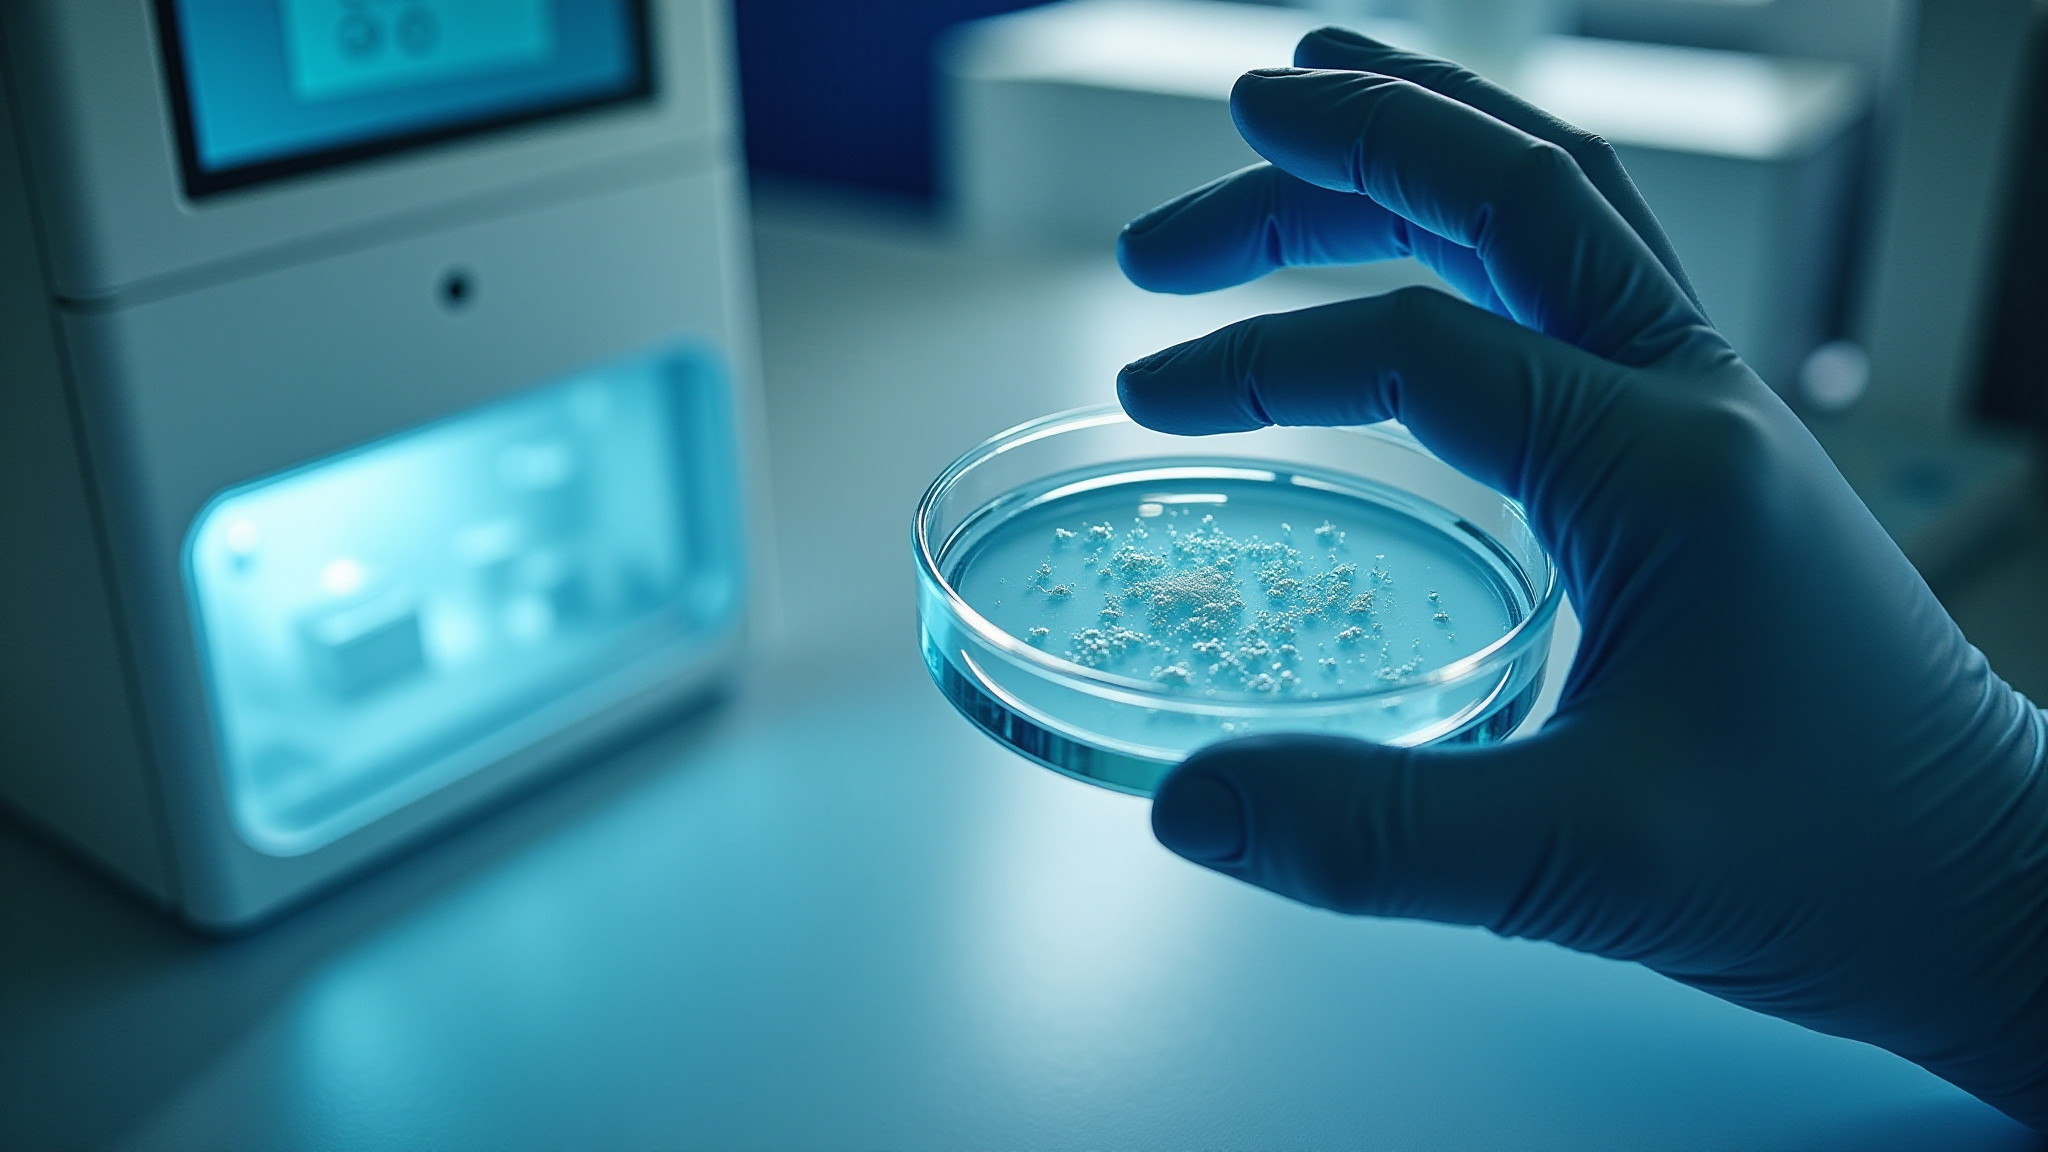

Shukare -Lab
Hampton University Cancer Center
Department of Chemistry & Biochemistry

We combine education and discovery to tackle some of today’s most pressing health challenges.
Mitochondrial Signaling in Cancer Progression
We investigate how mitochondrial metabolism and signaling fuel cancer growth, therapy resistance, and early metastatic changes. Using in-vitro cancer cell lines, 3D organoids, and zebrafish tumor xenograft models, we map the pathways that drive cancer aggressiveness.

Biological Determinants of Cancer Aggressiveness
We explore why certain cancers of African American ancestry display heightened aggressiveness, focusing on invasion and metastasis. Using patient‑derived cell lines and zebrafish models, we track how these tumors spread and identify factors that contribute to their behavior. We also examine how radiation influences these tumors and uncover mechanisms underlying radioresistance.
Tumor–Host Metabolic Crosstalk and Cachexia
We study how cancer reprograms mitochondrial function in adipocytes and skeletal muscle, uncovering the mechanisms that drive tissue wasting. By modeling interactions among cancer cells, fat cells, and muscle cells, we aim to identify novel signaling routes that regulate metabolism and contribute to cancer-induced cachexia.

Discovering Cancer Therapeutics from Medicinal Plants
We search for and study new and novel medicinal plants with potential anti-cancer activity. Our research focuses on identifying, isolating, and characterizing bioactive compounds that can kill cancer cells or inhibit their growth. We test these compounds using in-vitro cancer cell lines, 3D organoids, and zebrafish models to evaluate their therapeutic potential and mechanisms of action.

Amla